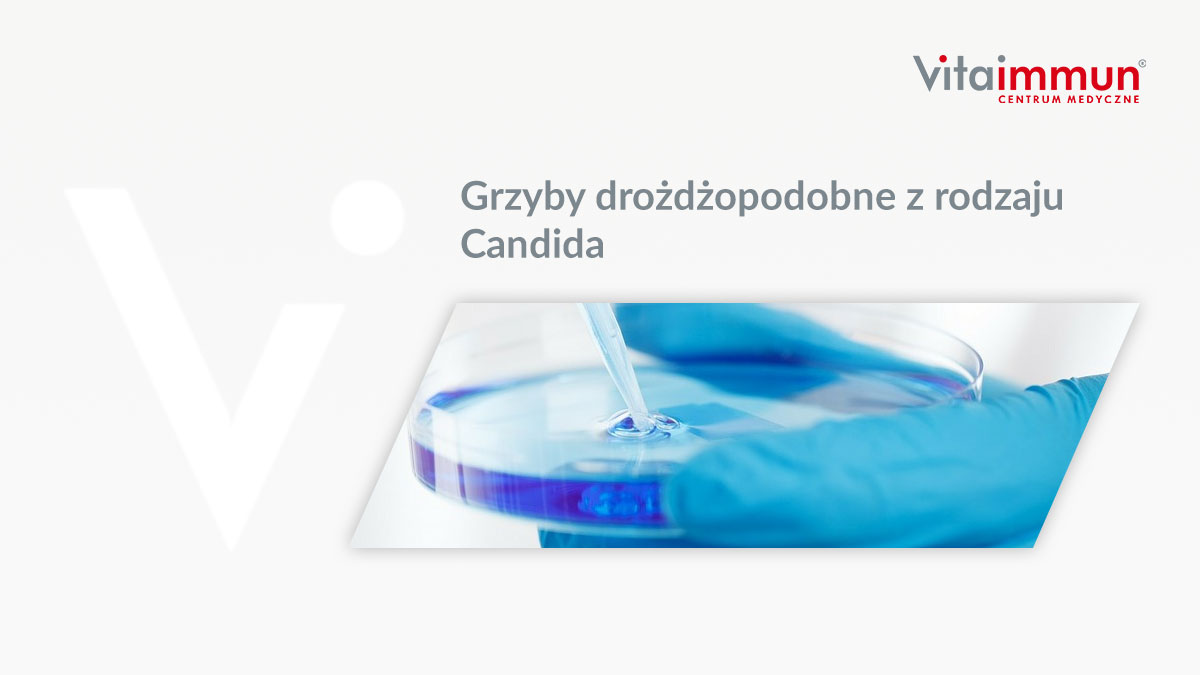
Grzyby drożdżopodobne z rodzaju Candida

Tag Archives: dysbioza jelitowa
OD PRÓBKI DO WYNIKU – co się dzieje w laboratorium VitaImmun?
Od próbki do wyniku, czyli co się dzieje z twoim materiałem, gdy trafia do Centrum Medycznego VitaImmun? Wyjaśni Wam to inż. Martyna Ha...
Grzyby drożdżopodobne z rodzaju Candida
Candida są drożdżopodobnymi grzybami, które można znaleźć na skórze oraz w błonach śluzowych układu oddechowego i moczowo-płciowego czł...
NAJNOWSZE DONIESIENIA DIETETYCZNE
Czy smog wpływa negatywnie na nasz mikrobiom jelitowy?
Smog obecnie stanowi problem w wielu krajach na świecie i wciąż brakuje skutecz...
Powiązania pomiędzy stanem zdrowia psychicznego a dietą
Przewód pokarmowy i zachodzące w nim procesy mają olbrzymi wpływ na nasz nastrój i samopoczucie. Coraz częściej mówi się więc o nowej g...
Dlaczego moje dziecko ciągle choruje?
Nawracające infekcje dróg oddechowych są przede wszystkim domeną okresu wczesnego dzieciństwa, choć dotykają także osób dorosłych....